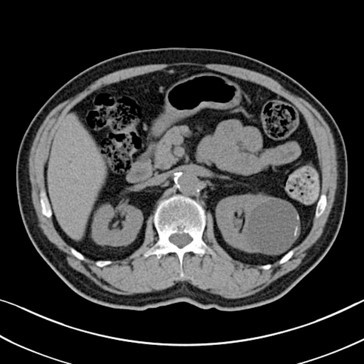

medullary nephrocalcinosis


bosniak classifcation?
2F

bosniak classification?

bosniak I
no septa, very simple

what bosniak classification do you follow?
bosniak 2F
which bosniak classifications do you excise?
3 and 4
diabetic

emphysematous pyelonephritis
is this mass enhancing?

yes!

new finding. Management?

excise it

trauma grade

IV



Next step?

Take it out!!
masses with 3 or more septa are NOT multisepated but they are multiLOCULATED
two most common multilocated masses in an adult?
multilocular cystic nephroma and multilocular RCC
you cannot tell the difference between the two on imaging


history of schistosomiasis





schistosomiasis


fever and leukocytosis

pyelonephritis with right renal vein thrombus

XGP with staghorn calc


UPJ crossing vessel


retroperitoneal liposarcoma
10–15% of all liposarcomas arise from the retroperitoneum

retroperitoneal fibrosis
50F

Mixed epithelial and stromal tumor (MEST)